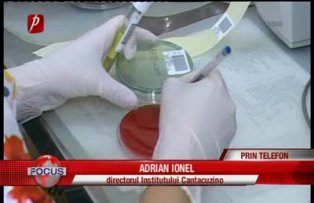

Brânza proaspătă de vaci de la Brădet şi carnea de pui dintr-o gospodărie din Bacău nu sunt sursa îmbolnăvirilor copiilor cu sindrom hemolitic uremic. Rezultatele date de Institutul Cantacuzino arată că, în cazul a 3 copii din Argeş, Sibiu şi Bacău, tulpinile de e.ecoli sunt diferite, deci nu poate fi vorba de o epidemie. În plus, probele alimentare analizate au demonstrat că brânza şi carnea de pui nu i-au îmbolnăvit pe copii, pentru că, şi în acest caz, tulpinile de EŞERIHIA COLI O 26 din alimente au fost diferite de bacteriile din organismul micuţilor.
ADRIAN IONEL, directorul Institutului Cantacuzino
Nu este date epidemiologice sugestive că aceste alimente ar fi fost consumate de vreunul dintre copii, iar tulpinile diferă faţă de cele recoltate la copii.
După mai bine de o lună de la primele cazuri de îmbolnăviri, la Spitalul Marie Curie din Capitală mai sunt internaţi 3 copii. Doar unul dintre ei mai are nevoie de dializă, dar starea lui este stabilă. Ceilalţi doi vor putea pleca acasă la sfârşitul acestei săptămâni.